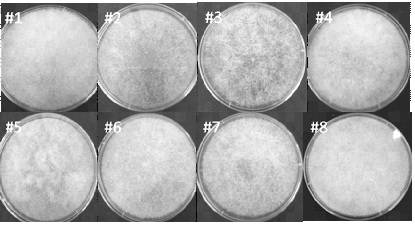
一种新型米根霉菌株g1及其培养方法和应用-爱企查

米根霉

生长在琼脂平板上的米根霉
图片尺寸1200x795
米根霉菌球体单罐半连续高强度发酵高光学纯度l-乳酸新工艺方法
图片尺寸786x592
米根霉ch5及其在提取紫芝多糖中的应用的制作方法
图片尺寸1000x967
米根霉 - 百度百科
图片尺寸725x654
时间温度和根霉菌的魔法
图片尺寸1080x810
米根霉 sicc 3.59
图片尺寸640x425
米根霉
图片尺寸525x522
米根霉沪酿3.866米酒曲根霉菌米酒发酵菌种厂家直销100克每袋
图片尺寸800x800
一种米根霉菌及其发酵百药煎的方法技术
图片尺寸839x428
米根霉
图片尺寸150x113
8)食品中常见的霉菌--根霉
图片尺寸656x446
酿酒培菌的重要性与过程
图片尺寸1080x1440
一股香味扑鼻而来……咦?黑色小绒毛?哈哈,这是一种菌类——根霉菌.
图片尺寸2160x1738
生产车间的霉菌多为青霉,米根霉,黄绿青霉,橘青霉,圆弧青霉,岛
图片尺寸400x267
这就是我们所取的根霉
图片尺寸2080x1560
米根霉
图片尺寸150x113
一种新型米根霉菌株g1及其培养方法和应用-爱企查
图片尺寸415x226
生活常识 米酒进入发酵阶段后,尽量不要打开盖子或搅动米酒,一段
图片尺寸800x320
米根霉
图片尺寸268x201
根霉是一种常见的腐生真菌.在显微镜下观察面包根霉.
图片尺寸1200x800